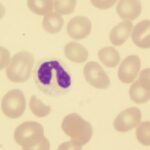
Study: Lower Educational Attainment Is Barrier to HCT for Patients with AML
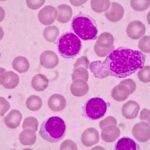
Zanubrutinib Shows Sustained Progression-Free Survival at Five Years

Smoking Affects Genetic Mutations and Progression of MDS
Recent research indicates that tobacco smoking is associated with distinct genetic mutations related to myelodysplastic syndromes (MDS). The study found that increased intensity and...
Study: Lower Educational Attainment Is Barrier to HCT for Patients with AML
Recent research reveals that socioeconomic status (SES), particularly lower educational attainment, can be a barrier to allogeneic hematopoietic cell transplantation(allo-HCT) among patients with acute...
Eptacog Beta Relieves Pain in Patients with Hemophilia
Eptacog beta relieved pain at 12 and 24 hours in patients with hemophilia with inhibitors, according to research presented at the ASH Annual Meeting....
Zanubrutinib Shows Sustained Progression-Free Survival at Five Years
The next-generation Bruton tyrosine kinase (BTK) inhibitor zanubrutinib (zanu) provided sustained progression-free survival (PFS), as compared with bendamustine plus rituximab (BR), in patients with...